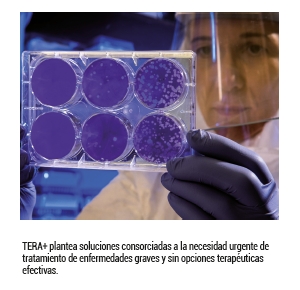

Abrir en el navegador
Abrir en el navegador
|

|

|
AseBio Te cuenta
|

|
El sector biotecnológico lidera el programa Doctores Industriales 2024 con casi la mitad de los proyectos seleccionados
La Agencia Estatal de Investigación (AEI) ha publicado la resolución definitiva del programa Doctores Industriales 2024, que...
Continuar leyendo
|
|

|
Bioga Comunica
|

|
La Asociación Cosmética Galega se integra en Bioga para reforzar la conexión entre cosmética y biotecnología
La Asociación Cosmética Galega (ACG), compuesta por 34 compañías gallegas del sector del cuidado personal, se...
Continuar leyendo
|
|

|
Actualidad de Farmabiotec
|

|
Ysios Capital refuerza su apuesta por la biotecnología con una nueva inversión en Neurona Therapeutics
Ysios Capital, gestora española especializada en inversiones en biotecnología, ha anunciado su participación en la...
Continuar leyendo
|
|

|

|
Werfen presenta AVITI, una innovadora plataforma de secuenciación genética para España
Werfen amplía su oferta de soluciones de secuenciación genética en España con el lanzamiento de AVITI, una plataforma...
Continuar leyendo
|
|

|
Navarra lanza el ambicioso Plan BioSintNA para liderar el desarrollo de la biología sintética en Europa
Navarra da un paso decisivo para posicionarse como referente europeo en biología sintética con la presentación del...
Continuar leyendo
|
|

|

|
Oryzon Genomics reafirma su compromiso con la vacunación infantil en colaboración con la Fundación "la Caixa" y Gavi
La compañía biofarmacéutica Oryzon Genomics S.A., líder europeo en epigenética y en fase clínica,...
Continuar leyendo
|
|

|
CESIF-metrodora y ComunicaBiotec se unen para impulsar la formación en biotecnología y salud
El Centro de Estudios Superiores de la Industria Farmacéutica (CESIF-metrodora) y la Asociación de Comunicadores...
Continuar leyendo
|
|

|

|
Un hallazgo clave en la lucha contra las superbacterias
Investigadores del Instituto de Química Física Blas Cabrera (IQF-CSIC) y la Universidad de Notre Dame (EE. UU.) han descubierto...
Continuar leyendo
|
|

|
Alliance Healthcare inicia una nueva etapa con su integración en Cencora
Alliance Healthcare, miembro de Cencora, ha iniciado un proceso de transformación que consolidará su evolución hacia...
Continuar leyendo
|
|

|

|
IMQ Ibérica organiza un webinar sobre cumplimiento normativo para exportación a Arabia e India
IMQ Ibérica organiza un webinar gratuito dirigido a empresas del sector cosmético y médico interesadas en la exportación...
Continuar leyendo
|
|

|
Formación en técnicas genómicas avanzadas: Genotipia lanza un curso universitario 100% online
Durante la pandemia de COVID-19, la técnica molecular PCR se hizo ampliamente conocida por su utilidad en la detección del...
Continuar leyendo
|
|

|

|
La EMA se presta al asesoramiento científico para dispositivos médicos de alto riesgo
La Agencia Europea de Medicamentos (EMA), en colaboración con la Comisión Europea, ha establecido un procedimiento estándar...
Continuar leyendo
|
|

|

|
Artículos
|

|
El dilema de los Sistemas Single Use: coste económico, operabilidad e impacto ambiental
La economía circular, la reutilización de recursos y la reducción de residuos dominan actualmente el discurso global de muchos sectores...
Artículo completo
|
|

|

|
La evolución de la tecnología farmacéutica: hacia una medicina más precisa y personalizada
La tecnología farmacéutica ha experimentado una evolución constante desde la antigüedad, adaptándose a los avances científicos...
Artículo completo
|
|

|
Evaluación Europea de Tecnologías Sanitarias: ¿qué implica para los productos sanitarios a partir de 2025?
Las tecnologías sanitarias, incluidos los productos sanitarios (PS), son esenciales para mejorar la salud y la calidad de vida de los pacientes. Para...
Artículo completo
|
|

|
Biomedicamento contra el síndrome inflamatorio derivado de infecciones pulmonares graves
La tormenta de citoquinas asociada a procesos infecciosos severos es un problema grave de salud mundial, ya que se registran alrededor de 49 millones de casos...
Artículo completo
|
|

|
Valtria, un referente en el diseño e instalación de salas limpias para proyectos de terapias avanzadas
Si hay algo que está revolucionando la medicina actual es la utilización de células, genes y tejidos como nuevos recursos terapéuticos....
Artículo completo
|
|
|
Nueva 'RICORS' (Redes de Investigación Cooperativa Orientadas a Resultados en Salud) en Terapias Avanzada: TERAV+
La propuesta española para ir un paso más allá de TERAV, y seguir generando resultados en salud con las terapias avanzadas.
TERAV+ se...
Artículo completo
|
|

|
ENVASES: nuevos requisitos en materia de etiquetado
El pasado 1 de enero de 2025, entraron en vigor las nuevas obligaciones de marcado e información asociadas a los envases y sus residuos, que las empresas...
Artículo completo
|
|

|
Retrosíntesis, su relevancia en química orgánica y en el desarrollo de fármacos
La retrosíntesis, introducida por E.J. Corey en los años 60, constituye una herramienta fundamental en la química sintética. Su...
Artículo completo
|
|

|
La insulina: El primer biofármaco y su impacto en la medicina moderna
La diabetes tipo 1 es una enfermedad que impide que el cuerpo produzca insulina, la hormona responsable de regular los niveles de azúcar en la sangre....
Artículo completo
|
|

|

|
Eventos recomendados
|

|
Farmaforum 2025
17/09/2025
IFEMA, Pabellón 9, Madrid (España)
Más información
|
|

|

|
BIOSPAIN 2025
07/10/2025
Fira de Barcelona - Gran Vía, Barcelona (España)
Más información
|
|

|
Medicalforum 2026
21/04/2026
Hotel Catalonia Plaza, Barcelona (España)
Más información
|
|

|

|
Empresas premium
|
|
|
|
Este mensaje y sus adjuntos contienen información confidencial y reservada dirigida exclusivamente a su destinatario. Si ha recibido este mensaje por error, se ruega lo notifique inmediatamente por esta misma vía y borre el mensaje de su sistema. Nótese que el correo electrónico vía Internet no permite asegurar ni la confidencialidad de los mensajes que se transmiten ni la correcta recepción de los mismos. Los datos derivados de su correspondencia se incluyen en un fichero de titularidad de OMNIMEDIA, S.L. cuya finalidad exclusiva es gestionar las comunicaciones de la empresa entendiéndose que usted consiente el tratamiento de los mismos con dicha finalidad al mantener tal correspondencia. El ejercicio de sus derechos de acceso, rectificación, cancelación u oposición puede realizarlo dirigiéndose por escrito a la dirección C/ Pollensa, 2, Edif. Artemisa of. 12 de LA ROZAS (28290 - MADRID) adjuntando una fotocopia de su NIF o documento identificativo.
Este mensaje se ha enviado a {{ campaign.sender.email }} que está registrado dentro del listado de suscriptores de nuestra revista. Si no desea recibir más información y darse de baja de nuestros boletines click aquí
|

































